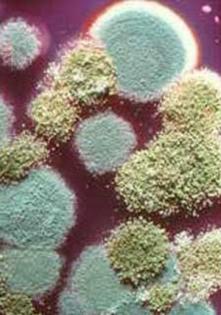
Schimmelprobleme in Duisburg

Schimmelprobleme in Duisburg
auf Anfrage
IDI15141711
18.01.2026
00088
Schimmelprobleme in Duisburg
Habe ich Schimmel in meiner Wohnung / meinem Haus ?
Wie konnte der Schimmel trotz ständigem Lüften entstehen ?
Wie kann man Schimmel feststellen ?
Was tun bei Schimmel ?
Ist Feuchtigkeit der Ursprung für das Entstehen des Schimmels ?
Wer hilft bei Auseinandersetzungen zwischen Mieter u. Vermieter
bei Schimmelproblemen ?
Wie konnte der Schimmel trotz ständigem Lüften entstehen ?
Wie kann man Schimmel feststellen ?
Was tun bei Schimmel ?
Ist Feuchtigkeit der Ursprung für das Entstehen des Schimmels ?
Wer hilft bei Auseinandersetzungen zwischen Mieter u. Vermieter
bei Schimmelproblemen ?
Weitere Einfamilien Häuser Anzeigen
Häufig gestellte Fragen
Im Menü Anzeigenverwaltung, auf den Button Nachricht schreiben klicken
Im Menü Anzeigenverwaltung, auf den Button Zur Merkliste hinzufügen klicken
Im Menü Anzeigenverwaltung, auf den Button Anzeige löschen klicken
I
Privater Anbieter
Aktiv seit 22.01.2021
Zeit sparen

Anzeigenverteiler Multiposting
Anzeige nur einmal schalten und auf mehreren Anzeigenmärkten gleichzeitig veröffentlichen.
Anzeigenverwaltung Multimanage
Anzeigen mit nur einen Klick auf mehreren Anzeigenportalen gleichzeitig bearbeiten oder löschen.
Besucher Statistiken
Detallierte Statistikdaten über Besucher der Anzeigen.
Weitere Einfamilien Häuser Anzeigen
Häufig gestellte Fragen
Im Menü Anzeigenverwaltung, auf den Button Nachricht schreiben klicken
Im Menü Anzeigenverwaltung, auf den Button Zur Merkliste hinzufügen klicken
Im Menü Anzeigenverwaltung, auf den Button Anzeige löschen klicken